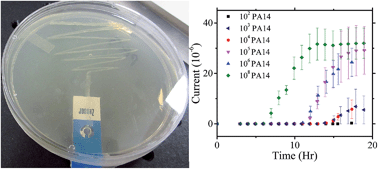
Graphical abstract: Improved monitoring of P. aeruginosa on agar plates

Improved monitoring of P. aeruginosa on agar plates†
Abstract
Described is the fabrication of a disposable electrochemical assay that is integrated with standard King's A agar culture plates, for the selective and specific detection of Pseudomonas aeruginosa. Agar plates provide several advantages over liquid culture, including protecting the sensor from biofouling and faster identification in small sample volumes. Cultures of P. aeruginosa, starting from initial cell counts of 102 to 108 cells in 5 microliter volumes, were incubated at 23, 37, and 42 °C and monitored both visually and electrochemically. Square wave voltammetry scans confirmed the production of a redox species, pyocyanin, over time that was dependent on the initial load of cells. The pyocyanin easily diffuses through the agar to reach the electrode surface. Using this simple and cheap approach, positive identification of P. aeruginosa was achieved several hours faster via electrochemical detection compared to traditional visual analysis.

- This article is part of the themed collection: Emerging Investigators
Please wait while we load your content...
Please wait while we load your content...